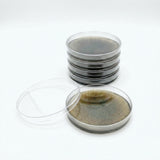
Stack of petri dishes with a transparent lid on a white background

Pre-Poured Willy’s Blend Manure Enriched Agar Plates - Conditioning Agar Plates (5-Pack)
Pre-Poured Willy’s Blend Manure Enriched Agar Plates - Conditioning Agar Plates (5-Pack) is backordered and will ship as soon as it is back in stock.
Couldn't load pickup availability
Description
Description
Condition Your Cultures for Maximum Performance
Introducing the first agar plate designed specifically to prepare spores and mycelium for manure-based substrates—our Willy’s Blend Infused Agar Plates. Each 5-pack starts as our premium MEA formula, then is enriched with a sterilized infusion of authentic Willy’s Blend manure substrate, giving your culture a head start by adapting it to the exact nutrients it will encounter later.
Perfect for spores, transfers, clone work, and culture cleanup, these plates create an early nutrient profile that mimics bulk substrate—helping you identify the strongest, most substrate-ready genetics before you ever move to grain or a tub.
Unlike agar that sits in warehouses for weeks, we pour every batch fresh daily and seal it the same day in polyolefin packaging to guarantee maximum freshness and clarity.
Why Growers Love Our Willy’s Blend Conditioning Plates
• 5 Sterile Willy’s Blend Infused Agar Plates per pack
• Prepares cultures for manure-based substrates from their very first growth stage
• Premium MEA + Yeast Extract + Authentic Willy’s Blend infusion
• Machine-poured into Microppose professional-grade 90mm dishes
• Perfect for spores, isolation, clone work, and culture conditioning
• Fresh-poured daily and sealed to lock in freshness
• Store refrigerated and use within 3–4 weeks for best results
Lab-Precision Poured for Elite Consistency
Beginning April 2025, all plates are produced in our clean room using advanced MediaPrep and MediaFill sterile systems:
• Sterilized at 18 PSI for 30 minutes
• Dispensed at 25 ml per plate for perfect depth
• UV-C treated, capped, laser-labeled, and batch-verified
• Zero-handpour variation—every plate is identical
This ensures crystal-clear agar, perfect surface tension, and the most reliable mycelial behavior possible.
What Makes Manure-Infused Agar Different?
Traditional MEA provides rich nutrients but doesn’t match the environment of manure-based substrates. By adding a carefully filtered and sterilized infusion of real Willy’s Blend, these plates help your spores or mycelium:
• Pre-adapt to manure nutrition profiles
• Display stronger rhizomorphic growth earlier
• Transition more aggressively to grain and bulk
• Reduce lag time after inoculation into substrate
• Reveal genetics that perform best on manure-based grows
Your culture starts on the substrate it will live on. Giving you a major advantage.
How to Use These Plates
Use them exactly like standard agar:
- Add a drop of spore solution or a tissue wedge.
- Incubate for 3–7 days.
- Select the strongest, most manure-adapted mycelium.
- Transfer to grain, LC, or straight into production.
Your mycelium adapts sooner—your grow performs better.